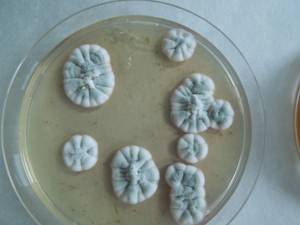
MSU_FS-01602 01, Район Тан Фу (Tân Phú districts), Đồng Nai province (Vietnam)

Total items: 2
Total pages: 1
Organisms

- Specimen ID
- 0000002675798
- Species
- Penicillium raperi
- Strain
- F-495
- Place of isolation
- (Uganda)
- Specimen ID
- 0000000904504
- Species
- Penicillium raperi
- Strain
- MSU_FS-01602
- Place of isolation
- Район Тан Фу (Tân Phú districts), Đồng Nai province (Vietnam)
- Placename
- Нам Кат Тьен (Nam Cát Tiên)